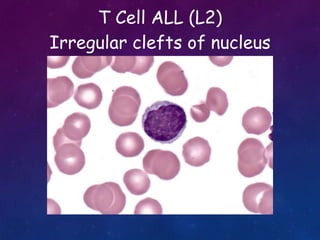
T Cell ALL (L2)
Irregular clefts of nucleus

Acute lymphoblastic leukemia (ALL) is a cancer of the lymphoid line of blood cells characterized by increased numbers of immature lymphocytes in the bone marrow. It is the most common cancer in children. Treatment involves chemotherapy given systemically and intrathecally in phases including induction, consolidation and maintenance to achieve and maintain remission. Prognosis depends on risk factors like age, white blood cell count, genetics. Late effects of intensive chemotherapy include secondary cancers, organ dysfunction. Relapse indicates poor prognosis requiring aggressive salvage therapies like stem cell transplant.